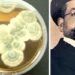
L’acqua ossigenata contro il Covid e Vincenzo Tiberio che anticipò Fleming

Il sovrano ottomano del XVI secolo, il sultano Suleiman I, che regnò per 46 anni, viene commemorato con una esposizione virtuale dal titolo “Kanuni Suleyman Devri” (”L’era del Sultano Suleiman il Magnifico”) per il 500o anniversario della sua ascesa al trono.
L’evento in rete comprende le conquiste del sultano, le sue battaglie e il suo regno durato 46 anni, il più lungo tra tutti i sultani ottomani, così come i suoi poemi scritti con lo pseudonimo di “Muhibbi” (che nella lingua turco-ottomana significa amichevole e appassionato).
La mostra raccoglie anche manoscritti dell’epoca del sultano, noto come Suleiman il Magnifico in Occidente e come Legislatore nel suo regno.
Sono esposte anche opere selezionate dalla Biblioteca Suleymaniye che possiede la più grande collezione di manoscritti della Turchia, e pezzi provenienti dalle Biblioteche Koprulu, Atif Efendi, Nuruosmaniye e Ragip Pasha.
I visitatori hanno l’opportunità di osservare i 46 manoscritti che descrivono nel dettaglio il regno del sultano Suleiman I, e allo stesso tempo acquisire una migliore comprensione delle arti e della cultura ottomana, insieme all’impero che ha governato oltre 25 milioni di persone in tre continenti durante l’epoca del sultano Suleiman.
Hanno la possibilità di rivivere la campagna di Belgrado del sultano attraverso le parole di Feridun Ahmed Bey, un influente ufficiale ottomano e autore, vissuto nel XVI secolo.
La conquista di Rodi da parte di Suleiman I viene raccontata da Ibn Kemal, conosciuto come Kemalpasazade, lo Sheikh al-Islam (sommo funzionario religioso nominato dal governo) e storico stimato.
La morte del sultano avvenne nel 1566 durante l’assedio di Szigetvar, nel Regno di Ungheria, e viene descritta nei documenti dallo studioso e cronista ottomano Selaniki Mustafa Efendi, conosciuto anche come Mustafa di Salonica (denominata oggi Salonicco).
Molti eventi e personaggi storici sono presentati nella mostra che crea un ritratto cronologico del governo del sultano e della storia dell’Impero Ottomano. Opere di illustri artisti dell’epoca, come il miniaturista e cesellatore Karamemi, il calligrafo Ahmed Karahisari e il poeta Baki, noto anche come il “Sultano dei Poeti”, sono incluse nell’esposizione, fornendo un contesto più approfondito.